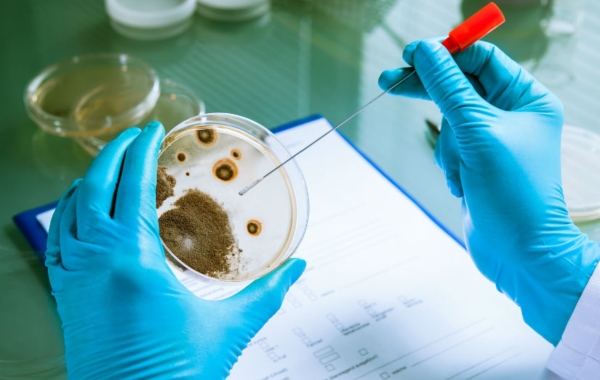
Công nghệ vi sinh là lĩnh vực ứng dụng hoạt động sống của vi sinh vật có lợi để phục vụ đời sống và sản xuất công nghiệp

Công nghệ vi sinh vật đang trở thành xu hướng được nhiều ngành ưu tiên phát triển nhờ khả năng cải thiện môi trường, nâng cao hiệu quả sản xuất và tiết kiệm chi phí. Dù xuất hiện ngày càng phổ biến, nhưng không phải ai cũng hiểu rõ công nghệ vi sinh vật là gì, hoạt động ra sao và mang lại lợi ích cụ thể như thế nào trong đời sống. Để nắm trọn kiến thức nền tảng và các ứng dụng thực tiễn nhất, bạn hãy tiếp tục theo dõi bài viết chi tiết của MT ngay dưới đây.
Công nghệ vi sinh vật là gì?
Công nghệ vi sinh vật là lĩnh vực khoa học – kỹ thuật ứng dụng các hoạt động sống của vi sinh vật (vi khuẩn, nấm, tảo, virus có lợi…) nhằm phục vụ đời sống con người và sản xuất công nghiệp. Đây là một nhánh của công nghệ sinh học, sử dụng kỹ thuật nuôi cấy, lên men, chế biến sinh học và biến đổi gene để khai thác các chức năng độc đáo của vi sinh vật.
Trong bối cảnh phát triển bền vững và kinh tế xanh, công nghệ vi sinh mang lại giải pháp sinh học thân thiện, tiết kiệm, hiệu quả cho nhiều bài toán môi trường nuôi cấy và sản xuất, từ phân giải các chất hữu cơ trong nước thải cho đến cải tạo đất nông nghiệp và sản xuất vaccine.
Các chủng vi sinh vật chủ lực gồm:
- Vi khuẩn cố định đạm, phân giải cellulose, khử kim loại nặng (Pseudomonas, Azotobacter…)
- Nấm men/nấm mốc dùng trong lên men và sản xuất enzyme (Saccharomyces cerevisiae, Aspergillus…)
- Tảo, đặc biệt là tảo lục và tảo lam với tiềm năng sinh năng lượng sinh học và xử lý nước.
Công nghệ vi sinh vật có vai trò nền tảng trong các hệ thống xử lý chất thải, công nghiệp thực phẩm, y dược, nông nghiệp và năng lượng tái tạo.
Đọc thêm:
Ưu điểm của công nghệ vi sinh
Với sự hỗ trợ của công nghệ hiện đại, công nghệ vi sinh vật mang đến nhiều lợi ích vượt trội cho môi trường, nông nghiệp và công nghiệp. Cụ thể:
- Thân thiện với môi trường: Hạn chế tối đa việc sử dụng hóa chất độc hại trong xử lý và sản xuất.
- Chi phí hợp lý: Dễ triển khai tại các mô hình nông nghiệp, sản xuất vừa và nhỏ của Việt Nam.
- Xử lý ô nhiễm hiệu quả: Đặc biệt phù hợp cho nước thải sinh hoạt, chăn nuôi và một số ngành công nghiệp nhẹ.
- Tăng năng suất nông nghiệp bền vững: Cải thiện hệ vi sinh đất, giảm suy thoái đất và tăng độ phì tự nhiên.
- Kết hợp tốt với công nghệ mới: Dễ tích hợp IoT, AI để giám sát và tự động hóa quy trình xử lý sinh học.
- Thúc đẩy công nghiệp phụ trợ: Là nền tảng phát triển enzyme, vaccine, chế phẩm sinh học và ngành dược nội địa.

Hiện nay, công nghệ vi sinh tại Việt Nam không chỉ kế thừa nền tảng khoa học hiện có mà còn phát triển mạnh nhờ sự kết hợp giữa nghiên cứu bản địa, phong trào khởi nghiệp và chính sách khuyến khích từ Nhà nước. Những yếu tố này tạo nên hệ sinh thái vi sinh ngày càng hoàn thiện và giàu tiềm năng.
Các điểm nổi bật gồm:
- Nhiều viện nghiên cứu lớn như Viện Công nghệ Sinh học – Viện Hàn lâm Khoa học và Công nghệ Việt Nam đang tập trung phát triển các chủng vi sinh bản địa phù hợp điều kiện khí hậu, đất đai Việt Nam.
- Sự xuất hiện của nhiều doanh nghiệp khởi nghiệp trong lĩnh vực phân bón vi sinh, chế phẩm sinh học và xử lý nước thải, góp phần thương mại hóa các sản phẩm vi sinh trong nước.
- Chính sách hỗ trợ đổi mới sáng tạo trong nông nghiệp công nghệ cao và năng lượng xanh, tạo động lực thúc đẩy nghiên cứu và ứng dụng công nghệ vi sinh vào thực tiễn.
Ứng dụng công nghệ vi sinh vật
Công nghệ vi sinh đang trở thành một trong những trụ cột của khoa học hiện đại, cho phép con người khai thác khả năng tự nhiên của vi sinh vật để phục vụ đời sống và sản xuất. Nhờ sự kết hợp giữa công nghệ – sinh học – tự động hóa, các ứng dụng vi sinh vật này ngày càng mạnh mẽ và đa dạng trong nhiều lĩnh vực khác nhau.
Ứng dụng trong lĩnh vực nghiên cứu khoa học
Vi sinh vật là mô hình nghiên cứu quan trọng trong sinh học phân tử, di truyền học và công nghệ gene. Nhờ đặc tính sinh trưởng nhanh, dễ nuôi cấy, chúng được sử dụng để:
- Nghiên cứu cấu trúc và chức năng của gene, làm cơ sở cho các phát minh về vaccine, dược phẩm và sinh học tổng hợp.
- Tạo vi sinh vật biến đổi gene như E.coli tái tổ hợp mang gene người để sản xuất protein, enzyme hoặc hormone phục vụ điều trị.
- Phát triển enzyme công nghiệp, được dùng trong dệt may, chế biến thực phẩm, chăn nuôi và năng lượng sinh học.
- Mô hình hóa quá trình sinh học, giúp khoa học hiểu rõ cơ chế gây bệnh, cơ chế kháng thuốc và quá trình trao đổi chất của tế bào.
Ứng dụng công nghệ vi sinh trong y tế
Công nghệ vi sinh vật đóng vai trò nòng cốt trong ngành y học hiện đại nhờ khả năng sản xuất dược phẩm và hỗ trợ chẩn đoán. Công nghệ này giúp giảm chi phí, tăng năng suất sản xuất dược phẩm và mở ra cơ hội điều trị mới. Các ứng dụng cụ thể như:
- Sản xuất kháng sinh, thuốc chống nấm, thuốc kháng virus thông qua quá trình lên men vi sinh (penicillin, streptomycin…).
- Sản xuất vaccine như vaccine cúm, viêm gan, thương hàn dựa trên nuôi cấy tế bào và vi sinh vật.
- Ứng dụng trong xét nghiệm y học như PCR, ELISA, nuôi cấy vi khuẩn giúp phát hiện mầm bệnh nhanh và chính xác.
- Sản xuất protein tái tổ hợp như insulin, hormone tăng trưởng và các loại protein trị liệu bằng vi sinh vật mang gene người.

Ứng dụng công nghệ vi sinh trong nuôi trồng thủy sản
Ngành thủy sản dựa nhiều vào công nghệ vi sinh vật để kiểm soát môi trường và bảo vệ vật nuôi. Các ứng dụng này giúp:
- Cải thiện chất lượng nước ao nuôi nhờ các chủng Nitrosomonas, Nitrobacter chuyển hóa amoniac – nitrit độc thành nitrat an toàn.
- Phòng và trị bệnh thủy sản thông qua chế phẩm vi sinh đối kháng, giúp ức chế vi khuẩn gây bệnh như Vibrio spp.
- Giảm mùi hôi và xử lý bùn đáy, nhờ vi sinh vật phân giải chất hữu cơ, giảm ô nhiễm và hạn chế hiện tượng tảo độc bùng phát.
- Tăng sức đề kháng cho tôm cá bằng probiotic trộn thức ăn, giúp tăng tỷ lệ sống và tăng trưởng ổn định.
Đọc thêm: Kiểm soát vi sinh vật trong thực phẩm
Ứng dụng công nghệ vi sinh trong xử lý môi trường
Trong lĩnh vực này, công nghệ vi sinh vật phát huy hiệu quả mạnh mẽ nhờ khả năng phân hủy tự nhiên và xử lý chất thải. Qua đó giúp giảm ô nhiễm, phục hồi hệ sinh thái và thay thế nhiều hóa chất độc hại:
- Xử lý nước thải với hệ vi sinh hiếu khí, kỵ khí giúp phân giải BOD, COD, Amoni, Nitrat trong nước thải sinh hoạt và công nghiệp.
- Phục hồi môi trường (Bioremediation) bằng vi sinh vật phân hủy dầu loang, hóa chất độc hại hoặc kim loại nặng trong đất và nước.
- Xử lý rác thải rắn bằng công nghệ compost, giúp phân hủy rác hữu cơ và tạo phân bón sinh học chất lượng cao.
- Khắc phục sự cố tràn dầu, một số chủng vi khuẩn có khả năng “ăn” dầu mỏ, giúp làm sạch biển và đất bị ô nhiễm.
Ứng dụng công nghệ vi sinh trong ngành nông nghiệp
Công nghệ vi sinh vật trong nông nghiệp góp phần cải thiện đất, tăng năng suất và giảm chi phí phân bón. Một số ứng dụng tiêu biểu là:
- Phân bón vi sinh giúp tăng độ phì nhiêu, cải thiện cấu trúc đất và phục hồi hệ vi sinh tự nhiên.
- Cố định đạm tự nhiên bằng Rhizobium cho cây họ đậu hoặc Azospirillum cho cây lúa, giúp giảm lượng phân đạm hóa học.
- Thuốc trừ sâu vi sinh như Bacillus thuringiensis (Bt) an toàn cho người, động vật và môi trường, nhưng vẫn hiệu quả trong kiểm soát sâu bệnh.
- Cải tạo đất thông qua vi sinh phân giải phốt-pho, kali, hoặc phân hủy kim loại nặng ở đất bị thoái hóa.

Ứng dụng công nghệ vi sinh trong chăn nuôi
Vi sinh vật được xem là “giải pháp xanh” thay thế kháng sinh và hóa chất trong chăn nuôi. Một số ứng dụng thực tế của công nghệ này là:
- Men vi sinh (probiotic) hỗ trợ tiêu hóa, tăng khả năng hấp thu dinh dưỡng và giảm bệnh đường ruột ở gia súc gia cầm.
- Giảm mùi hôi chuồng trại, nhờ vi sinh vật phân giải phân – nước tiểu, hạn chế khí độc như NH3 và H2S.
- Tăng cường miễn dịch tự nhiên, giúp đàn vật nuôi khỏe mạnh hơn và giảm phụ thuộc vào kháng sinh.
- Xử lý chất thải chăn nuôi, giảm ô nhiễm và hỗ trợ sản xuất biogas.
Tóm lại, công nghệ vi sinh vật đang mở ra những cơ hội to lớn cho các ngành nông nghiệp, dược phẩm, năng lượng và môi trường, đồng thời mang lại giải pháp bền vững và tiết kiệm chi phí sản xuất. Để khai thác tối đa tiềm năng này, việc ứng dụng thiết bị công nghệ sinh học hiện đại và giải pháp tự động là yếu tố then chốt.
Bên cạnh đó, MT là đơn vị tiên phong trong lĩnh vực thiết bị công nghệ sinh học luôn đồng hành cùng khách hàng, cung cấp các hệ thống lên men, hệ thống nuôi cấy Bioreactor, máy lên men vi sinh fermenter đáp ứng linh hoạt nhu cầu nghiên cứu, thử nghiệm và sản xuất ở nhiều quy mô khác nhau. Song song đó, các sản phẩm housing lọc, hệ thống lọc tiếp tuyến, hệ thống CIP & SIP và các hệ thống pha chế chất lượng cao. Những giải pháp này giúp quá trình nghiên cứu và ứng dụng công nghệ vi sinh vật đạt hiệu quả cao.
Liên hệ ngay với MT để được tư vấn và hỗ trợ giải pháp công nghệ sinh học toàn diện:
- Địa chỉ: TK40/10 Đường Trần Hưng Đạo, Phường Cầu Ông Lãnh, TP. Hồ Chí Minh, Việt Nam
- Hotline: 0767 067 567
- Email: infor@mtenequip.com



